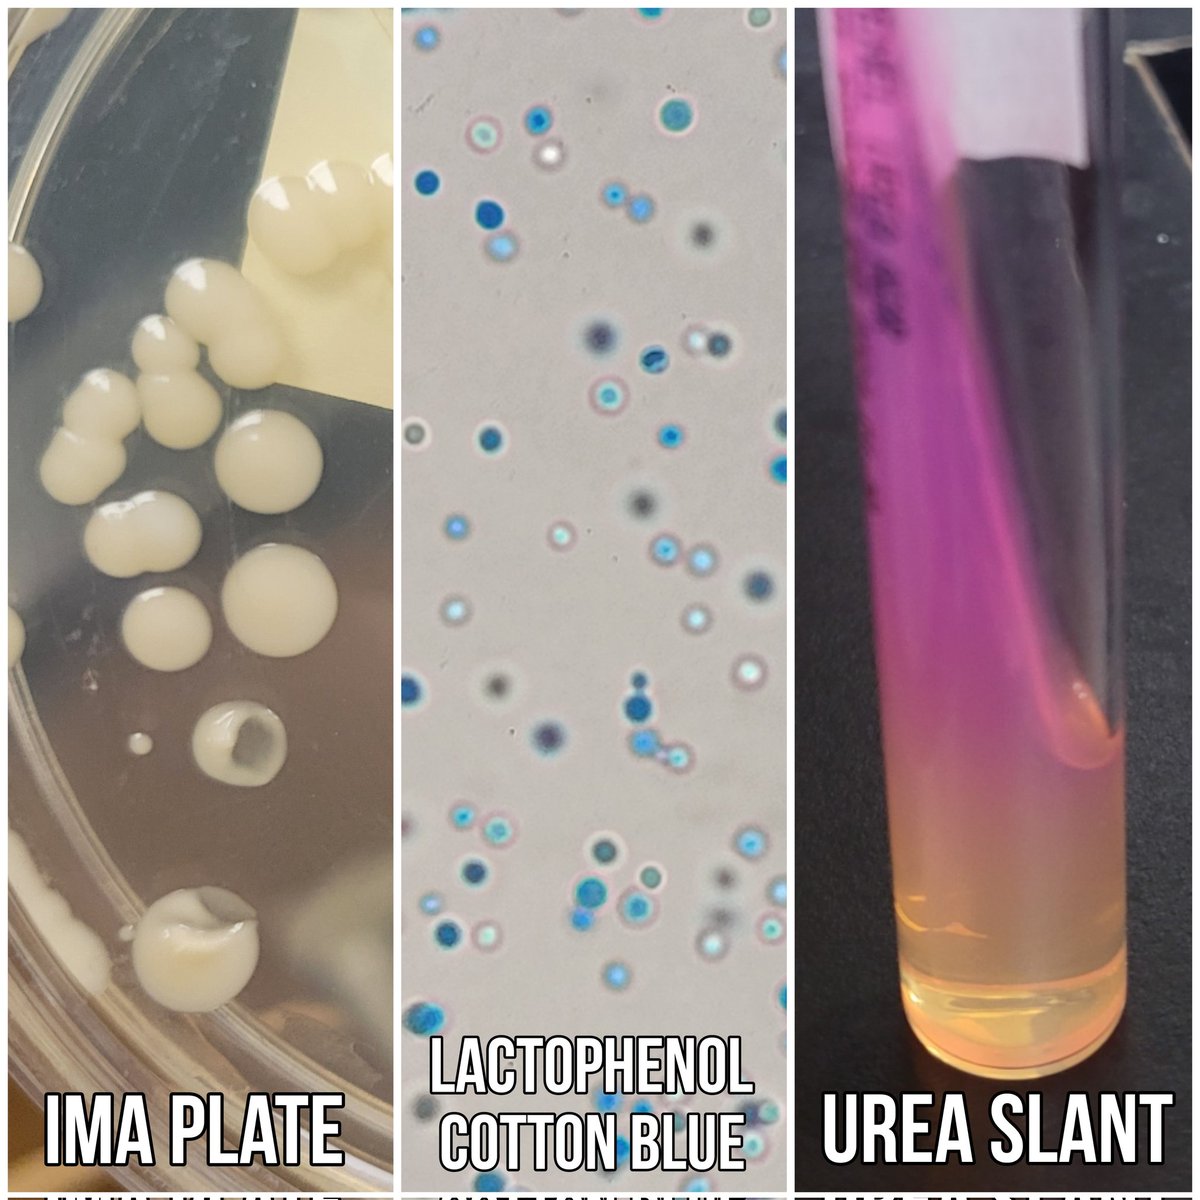
Julia Hankins, PhD, D(ABMM) tweet media

Sabitlenmiş Tweet

💊Time to learn some #antibiotics! So many to learn in #clinicalmicrobiology, so little time!😅So I'm starting from the basics 🧱+ building on it🏡. Will share as I learn, so others can have an intro resource 🔖. Input/corrections welcome + appreciated! 🙏

English